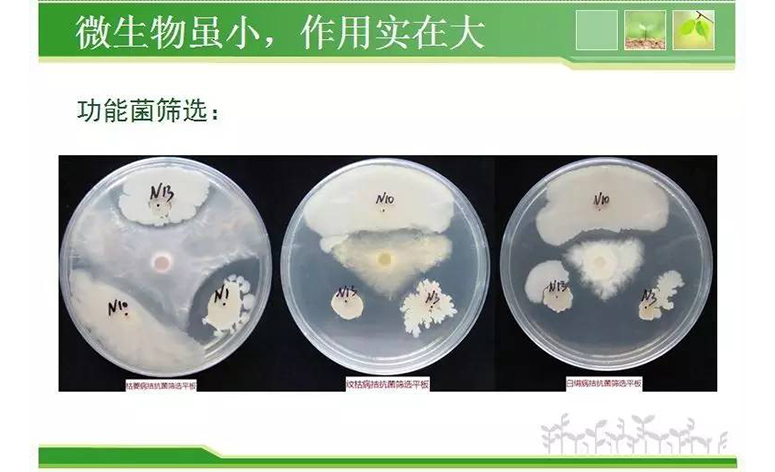
55.jpg

坤益健���,讓生活更美好
日期:2017-05-20 10:10:17
輕輕的����,坤益健來了��,
像一個幸福的天使��,
土壤健康了�����,秧苗健康了,
農(nóng)藥化肥催長劑少施了���,
人力物力成本減少了�,
污染也減少了��,
水清了���,樹綠了���,天更藍了�����,
環(huán)境更和諧了�����。
農(nóng)產(chǎn)品形色美觀了����,
提早上市了���,
口感新鮮濃郁了���,
人們吃出了曾經(jīng)苦苦尋覓,
安全放心又美味的老味道�����。
孩子們笑了�����,老人們笑了�,
農(nóng)民們笑了!
你們笑了���,我們也笑了��!
大家都笑了�!
坤益健���,讓生活更美好了......

坤益健生物有機肥
農(nóng)民買的放心�,用了開心��!
坤禾肥�����,為健康���!
土壤健康���,秧苗健康,
農(nóng)產(chǎn)品美味更健康�!